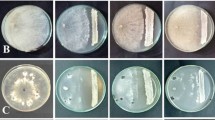

Abstract
In past few years, salinity has become one of the important abiotic stresses in the agricultural fields due to anthropogenic activities. Salinity is leading towards yield losses due to soil infertility and increasing vulnerability of crops to diseases. Fluorescent pseudomonads are a diverse group of soil microorganisms known for promoting plant growth by involving various traits including protecting crops from infection by the phytopathogens. In this investigation, salt tolerant plant growth promoting bacterium Pseudomonas hunanensis SPT26 was selected as an antagonist against Fusarium oxysporum, causal organism of fusarium wilt in tomato. P. hunanensis SPT26 was found capable to produce various antifungal metabolites. Characterization of purified metabolites using Fourier transform infrared spectroscopy (FT-IR) and liquid chromatography-electron spray ionization-mass spectrometry (LC-ESI/MS) showed the production of various antifungal compounds viz., pyrolnitrin, pyochelin and hyroxyphenazine by P. hunanensis SPT26. In the preliminary examination, biocontrol activity of purified antifungal metabolites was checked by dual culture method and results showed 68%, 52% and 65% growth inhibition by pyrolnitrin, 1- hydroxyphenazine and the bacterium (P. hunanensis SPT26) respectively. Images from scanning electron microscopy (SEM) revealed the damage to the mycelia of fungal phytopathogen due to production of antifungal compounds secreted by P. hunanensis SPT26. Application of bioinoculant of P. hunanensis SPT26 and purified metabolites significantly decreased the disease incidence in tomato and increased the plant growth parameters (root and shoot length, antioxidant activity, number of fruits per plant, etc.) under saline conditions. The study reports a novel bioinoculant formulation with the ability to promote plant growth parameters in tomato in presence of phytopathogens even under saline conditions.
Similar content being viewed by others
Avoid common mistakes on your manuscript.
Introduction
Tomato (Lycopersicum esculentum) belonging to the family Solanaceae and grown worldwide, is the second most important vegetable crop after potato. China and India are the top two producers of tomato with estimated cultivation of 67.64 million metric tonnes and 21 million metric tonnes respectively, in the year 2021 (STATISTICA 2022). But, due to various biotic and abiotic factors, the production of tomato is affected globally. Among the abiotic factors, soil salinization is one of the most prevailing stresses around the world, which is affecting the yield and quality of crops (Ors et al. 2021). Due to increasing salt level in the soil the world is going to face the loss of approximately 50% of cultivable land in next 30 years (Kumar and Sharma 2020; Arora et al. 2020). Salinity adversely affects the various developmental stages of plants including germination, photorespiration, transpiration, and reproduction. Besides the abiotic factors, tomato crop is also very prone to the infections caused by phytopathogens. Fusarium oxysporum f. sp. lycopersici is the soil-borne fungal phytopathogen that causes fusarium wilt, crown, and root rot diseases in the tomato (Larkin and Fravel 1998; Mohammed et al. 2020). Fusarium infects the tomato crop severely by infecting the root and crown of the plants by colonizing the vascular system, which disturbs the whole vital mechanisms decelerating the plant growth, wilting and eventually results in plant death. In the recent years, it has been reported that tomato crop is facing approximately 60–70% of yield loss due to infection of F. oxysporum (Murugan et al. 2020). Due to these factors, the world is experiencing a great loss in the crop yield, which is imposing a threat to the food security (Ramírez-Cariño et al. 2020). Farmers generally use pesticides for the protection of tomato crop from phytopathogens such as F. oxysporum. Pesticides have adverse effects on human health and on the ecosystem. Hence, there is a demand to utilize sustainable and greener methods for enhancing crop productivity with plant disease management.
Soil-borne pathogens could be eradicated by eco-friendly methods such as using the resistant varieties or by employing biocontrol agents (BCAs). Although the use of resistant tomato cultivars can reduce the disease incidence to some extent, the occurrence of novel races and evolution of pathogens sustains the problem (Castano et al. 2013). Biocontrol agents like Bacillus sp. and pseudomonads are well-known for controlling the infection of fungal phytopathogens. Pseudomonads have great potential to enhance the growth of plants and simultaneously protecting them from phytopathogens due to their versatility, adaptability, and ability to produce an array of metabolites. Halotolerant strains efficiently improve the plant growth and productivity under saline conditions by promoting the mineral solubilization and antioxidant activity (Arora et al. 2020, 2024; Mishra et al. 2024). They significantly maintain plant health with efficient root colonization, induction of host systemic resistance, antagonistic activity against pathogens, production of extracellular cell wall degrading enzymes, and secretion of antibiotics. Pseudomonads are known to produce several antibiotics including phenazine, pyocyanin, pyoverdines, 2,4-diacetylphloroglucinol (2,4-DAPG), pyoluteorin (PLT), pyrolnitrin (PRN) and pseudomonic acid (Fuller et al. 1971; Whistler and Peirson 2003; Chen et al. 2015; Mishra and Arora 2018; Schiessl et al. 2019; Zhang et al. 2020).
Pseudomonads are extensively being utilized as plant growth promoting rhizobacteria (PGPR), but there is limited research on their utilization for alleviation of combined impact of salinity and phytopathogens on crop. In this study, a salt tolerant PGPR (ST- PGPR) with biocontrol abilities is exploited to control the fusarium wilt of tomato under saline conditions. To determine the mechanisms of action, anti-fungal metabolites of the ST-PGPR were investigated. Effect of inoculation of the ST-PGPR on growth parameters of tomato were checked in presence of the phytopathogen F. oxysporum under saline conditions. Additionally, antifungal metabolites produced by the bacterium were also investigated to control the phytopathogen.
Materials and methods
Study site and collection of samples
Soil samples were collected from the rhizosphere of tomato growing under saline conditions in the region of Kanpur Dehat (26.7108° N, 79.7540° E), Uttar Pradesh, India. The samples were collected in the month of March, when minimum temperature was 26 °C and maximum 33.3 °C. Soil samples (rhizosphere) were collected from three different plants in sterile poly bags and immediately brought into the laboratory for testing. The pH and EC (electrical conductivity) was recorded to be in the range of 9.2 and 8.6 dS/m respectively, indicating saline nature of the soil.
Isolation of bacteria from the rhizosphere of tomato
Bacterial isolates were obtained from rhizosphere of tomato growing under saline stress. Further, cultures were streaked and maintained on KB agar by picking up colonies showing fluorescence. Fungal strain (F. oxysporum F84) was obtained from the National Agriculturally Important Microbial Culture Collection (NAIMCC), Mau, Uttar Pradesh, India. Fungal culture was revived on potato dextrose agar (PDA) and incubated for 5–7 days at 30 °C. Bacterial and fungal cultures were preserved for further analysis in slants of KB agar and PDA respectively, in refrigerator at 4 °C and sub-cultured at regular time intervals. Cultures were also preserved in glycerol stock under − 86 °C.
Preliminary screening of salt tolerance and antagonistic activities of isolates against F. oxysporum
In vitro screening of all 46 isolates for salt tolerance was checked by observing growth on the KB agar containing NaCl in concentrations (1–10%). Medium without salt was taken as control. The efficacy of salt tolerant isolates for biocontrol potential under different salt levels (1- 10%) against F. oxysporum was checked on PDA plates by dual culture technique (Kandoliya and Vakharia 2013). Inhibition of fungal growth was compared with the fungal growth in the control plate with no bacterial inoculation, and the observed difference was recorded. Three replicates were taken for each isolate. Percentage of growth inhibition of F. oxysporum was measured and calculated using the formula:
Inhibition percentage of fungal growth (I) = \(\:\frac{C-T}{C}X\:100\)
Where, C is mycelial growth of F. oxysporum in control plate (in cm),
T is mycelial growth of F. oxysporum in plates co-inoculated with bacterial isolates (in cm).
Molecular identification of selected isolate SPT26
Isolate SPT26 was selected on basis of its salt tolerance and antagonistic properties against the fungal pathogen for sequencing. For this 16 S rRNA gene 1200 bp was amplified with universal bacterial primers (27 F 5′-AGAGTTTGATCMTGGCTCAG-3′ and 1541 R 5′-AAG GAG GTG ATC CAG CCG CA-3′) using polymerase chain reaction (PCR) according to George et al. (2015). The resulted high-quality sequences were analysed with BLASTn (NCBI) to confirm the authenticity of the bacterium. The sequence was subjected to basic local alignment search tool (BLAST) analysis using the online option available at http://www.ncbi.nlm.nih.gov/BLAST. Nucleotide-BLAST was used to identify the sequence homology. The gene sequence was submitted in the NCBI for accession number. Distance matrices were computed via Mega X software version 4.0 using Neighbour Joining method (Tamura et al. 2007). Relative support for specific clades, represented in the tree was estimated by bootstrap analysis of 100 replicates. Nucleotide divergences were estimated using Kimura’s two-parameter method. Sequence data analysis was carried out by a stepwise approach. Isolate SPT26 was submitted at National Agriculturally Important Microbial Culture Collection (NAIMCC), Mau, India, an international culture repository, which is approved by International Depository Authority (IDA).
Extraction and Fourier transform infrared (FT-IR) spectroscopy of extracted antifungal metabolites
Extraction of metabolites produced by the isolate SPT26 was done according to Rosales et al. (1995). Briefly, freshly grown loopful culture was inoculated in King’s B broth medium (250 ml) supplemented with glycerol and 5% NaCl. Culture was further incubated with shaking at 100 rpm at 28 °C for 72 h. After that, broth culture was centrifuged at 10,000 rpm for 15 min at 4 °C temperature. Supernatant of culture was separated, and its pH was reduced to 3.0 using 3 M hydrochloric acid to denature the enzymes produced. Metabolites from samples were extracted using supernatant and ethyl acetate (1:1) in separating funnel. The sample was shaken vigorously for 30 min and separating funnel was placed stable for 10–15 min. Later, organic layer of ethyl acetate was separated, and this extraction was repeated with supernatant portion using 150 ml ethyl acetate. Obtained layers of ethyl acetate were combined and evaporated under reduced pressure using rotary evaporator. Procured residues were dissolved in 2.5 ml of methanol (LCMS grade).
FT-IR spectroscopy of extracted metabolites was performed for identification of organic and inorganic functional groups. Extracted compounds from isolate SPT26 were dried in absence of light under room temperature for 24–48 h. The obtained compounds were mixed with potassium bromide (KBr) in ratio 1:30 and pellet preparation was done as described by Prakash and Arora (2021). Further, pellets were analyzed under FT-IR spectrophotometer (Model: NicoletTM 6700, ThermoFisher Scientific, USA) at the wavelength range of 500–4500 cm− 1.
Purification of antifungal compounds from crude metabolite extracted from culture supernatant through thin layer chromatography (TLC)
Extracted metabolite was subjected for the TLC for purification of the antifungal compounds as described by Prakash and Arora (2021). TLC plates coated with 250 μm thick layer of silica gel were activated by keeping the plates at 110℃ for one hour just before use. A line was drawn on TLC plate with the help of pencil with margin of 1 cm and 10 µl of metabolite sample was spotted at two or three places on the drawn line. Spots on TLC were developed by using acetonitrile: methanol: water (1:1:1) as solvent. Plates were observed under short wavelength UV light at 254 nm and after spraying with diazotized sulfanilic acid (DSA). The active spots were scraped from plates and dissolved in 100 µl of methanol followed by centrifuging at 8000 rpm for 15 min for separating the silica from the metabolite. Purified metabolites were then assayed for antagonistic activity against F. oxysporum.
Antifungal activity of purified metabolite from culture supernatant against F. oxysporum
Estimation of antifungal activity of purified metabolites in normal and saline conditions was done by the well diffusion method (Perez et al. 1990). Muler Hinton agar (MHA) plates with different salt levels (1-10%) and without salt were prepared and fungal spore suspension of cfu (colony forming unit) 3 × 106 in 0.5 McFarland solution was spread on the plates. Wells of volume of approximately 100 µL were made in the centre of plates with the help of cork-borer. However, wells were not made in the control plates. These wells were filled with the purified metabolites (10 mg/ml) and the plates were kept in the incubator at 28 °C for five days. After five days, the growth inhibition was observed and compared with control plates, and the zone of inhibition was measured.
Further, minimum inhibitory concentration (MIC) of antifungal compounds A and B was determined by well diffusion method (Perez et al. 1990). In this method, well with different concentrations (0.1%, 0.5%, 1%, 1.5%, 2%) of antifungal compounds A and B were tested for their activity of growth inhibition of F. oxysporum. Each experiment was carried out with three replicates.
Morphological and structural changes in challenged F. oxysporum
Morphological changes in mycelia were observed at ultrastructural level under scanning electron microscope (SEM) by comparing the images obtained of challenged fungus and non-challenged fungus (control). For determination of structural changes mycelia were taken from the zone of inhibition of fungal growth and primary fixation was done in 2.5% glutaraldehyde at 4 °C for 4–6 h. Fixed mycelia were then washed for three times in 0.1 M phosphate buffer. Post fixation was done by 1% osmium tetroxide for 2 h at 4 °C. Then, samples were again washed three times with 0.1 M phosphate buffer and dehydration was done in increasing concentration of acetone (30%, 50%, 70%, 90%, 95%, 100%) for removing water molecules from samples (Xu et al. 2020). This method was repeated for mycelia taken from control. Finally, samples were mounted on aluminium stubs with carbon tape and coated with gold using sputter coater for making sample conductive (MSC-101, JOEL). The prepared sample of the fungal mycelia were observed under SEM (Model: JSM:7610 F, JEOL, Japan).
Identification of antibiotics through liquid chromatography-electron spray ionization-mass spectrometry (LC-ESI/MS)
The purified antifungal metabolites were mixed with methanol (15-20 mg/ml) and subjected for characterization using liquid chromatography-electron spray ionization-mass spectrometry (LC-ESI/MS) technique using Water ultra-performance liquid chromatography-triple quadrupole photodiode (UPLC-TQD) mass spectrometer (Waters Corp., MA, USA) (Meliani et al. 2022). Chromatographic separation was achieved by the C18 column (250 × 4.6 mm, 5 μm pore size). Analysis was carried out with sample injection volume 10 µL, mobile phase at a rate of 1.5 mL/min.
Pot experiment and assessment of efficacy of metabolite against F. oxysporum in tomato
Pot study was carried out in the open greenhouse at the experimental field of Department of Environmental Science, Babasaheb Bhimrao Ambedkar University, Lucknow, India. The tomato variety (PUSA, from Punjab seeds Ltd. Lucknow, UP, India) was selected because of its ease of availability and good productivity. The seeds were sown in the saline soil with pH 9.2 and EC 8.6 dS/m, obtained from Kanpur Dehat, India for experimental purposes. The soil physico-chemical properties were characterised before and after the pot experiment (Table 1). Soil pH and EC were analysed according to standard protocol given by FAO (2021). Bacterial count in the soil samples was determined according to Dada and Aruwa (2014). Water holding capacity (WHC) of soil was checked according to Arora et al. (2024). Later, WHC of soil was calculated as:
WHC (%) = [(amount of water added to soil – amount of water left in measuring cylinder)/ amount of water added to soil] x 100.
Soil nitrogen and available phosphorus was estimated by Kjeldahl method and Olsen method respectively, as per given by FAO (2021). Soil Sodium (Na) and Potassium (K) content was checked according to the method given by Kumar and Rao (2017). In this method, soil extract was prepared and analyzed under flame photometer. Na and K content were calculated as follows:
Na (ppm) = Na concentration in ppm x dilution factor.
K (ppm) = K concentration in ppm x dilution factor.
Prior to sowing, surface sterilization of seeds was done using 3% sodium hypochlorite solution for 1 min following the washing of seeds three times with autoclaved double distilled water. Seed coating was done with the help of talc-based bioformulation, and seeds were treated with the bioformulation for overnight. Talc-based bioformulation was prepared according to the method described by Fatima et al. (2020). In brief, bacterial cell suspension was prepared by growing SPT26 in KB broth at 28 °C at 100 rpm. After 24 h, 100 ml of cell suspension was taken, and optical density (OD) was adjusted (to approximately 1.0) using autoclaved double distilled water. This suspension was further mixed in talc-cellulose mixture. Talc-cellulose mixture was prepared according to Nandakumar et al. (2001), calcium carbonate was mixed in 1 kg of talc at rate of 15 g/kg for adjustment of pH to 6.5 ± 0.2. Carboxymethyl cellulose (CMC) at rate of 1 g/kg of talc was added to mixture for enhancing binding characteristic of bioinoculant. After seed coating, seeds were sown in the saline soil. The experiment was conducted in triplicate and the treatments given were: Treatment 1 (control), Treatment 2 (negative control i.e., treated with spore suspension (3 × 108) of F. oxysporum), Treatment 3 (P. hunanensis SPT26), Treatment 4 (SPT26 + F. oxysporum), Treatment 5 (1% compound A + F. oxysporum), Treatment 6 (1% compound B + F. oxysporum), Treatment 7 (SPT26 + 1% compound A + F. oxysporum), Treatment 8 (SPT26 + 1% compound B + F. oxysporum), Treatment 9 (1% compound A + 1% compound B + F. oxysporum), Treatment 10 (SPT26 + 1% compound A + 1% compound B + F. oxysporum). The seedling germination was observed 15 DAS (days after sowing) and germination rate was calculated according to the formula (Fatima and Arora 2021):
The tomato plants grown in the pot were transplanted after attaining the growth of 30 DAS. Before transplantation, the seedlings were treated with root dip method according to the different treatments as mentioned above. Pots having height 24 cm and width 20 cm were selected and filled with saline soil and sand in the ratio of 3:1. One seedling of tomato per pot was transplanted and the pots were arranged randomly with completely randomised block design (CRBD) arrangement having five replicates per treatment.
Assessment of effect of treatment on growth of tomato plants under saline conditions
After 90 days, plants were uprooted in mature fruiting stage and analyzed for various parameters such as, root length, shoot length, fresh weight, dry weight, relative water content and average number of fruits per plant was calculated. All the phytochemical parameters viz. photosynthetic pigments (chlorophyll-A, chlorophyll-B), carotenoid content, total phenolic content, carbohydrate, total soluble protein, proline, and flavonoid content were estimated spectrophotometrically in triplicates. Photosynthetic pigment and carotenoid content of plant sample were checked as per Porra et al. (1989). Total phenolic content was assessed using Follin-Ciocalteau method of Karimi et al. (2014). Carbohydrate content was estimated by anthrone carbohydrate test (Kumar et al. 2020). Total soluble protein was estimated as per Lowry et al. (1951), and flavonoid content was estimated according to Senguttuvan et al. (2014). Proline content was analysed in the samples according to the method given by Ábrahám et al. (2010).
Statistical analysis
All the experiments were repeated three times and data obtained from five replicates were statistically analyzed using SPSS (version 23) using one-way ANOVA. The significance of differences amongst all treatments were tested using Duncan multiple range test (DMRT) at P value of ≤ 0.05. Heatmap was plotted using MS Excel to envision the effects of various treatments on different plant biochemical parameters (P ≤ 0.05). Origin 2023 software (OriginLab, Massachusetts, USA) was used to plot the Pearson correlation graph to study the correlation between the various parameters of the plants.
Results
Preliminary screening of salt tolerance and antagonistic activities of isolates against F. oxysporum
In total 46 isolates were obtained from the rhizospheric soil of the tomato plant growing under saline conditions. All isolates were assayed for salt tolerance by observing growth under different salt concentrations. More than 50% of the isolates were not able to grow in saline conditions where as some isolates were able to grow at 3% and 5% NaCl. SPT26 and SPU19 were found to grow efficiently at 8% NaCl, while SPU31 and SPTc2 were able to grow at 10% salt concentration. Results obtained from the biocontrol test conducted against F. oxysporum revealed that SPU13 (26%) and SPU31 (43%) showed minimum inhibition, whereas SPU19 (75%) and SPT26 (65%) showed maximum inhibition of the phytopathogen (Supplementary Table 1). In presence of 5% salt SPU19 and SPT26 were able to inhibit the fungal growth by 70% and 62% respectively. Out of all the isolates, SPT26 and SPU19 were selected due to their salt tolerance and antagonistic behaviour against F. oxysporum (Supplementary Fig. 1).
Molecular identification of selected isolate SPT26
Isolate SPT26 showed 99% similarity with Pseudomonas hunanensis strain NR_178547.1, while SPU 19 showed similarity with Pseudomonas aeruginosa. Only SPT26 was selected for further studies as SPU 19 was identified as P. aeruginosa, which is a well-known opportunistic human pathogen. The sequence of the selected isolate SPT26 has been deposited in the NCBI GenBank Database under Accession Number PP152356.1. Isolate SPT26 was also deposited at NAIMCC, Mau India, with the accession number NAIMCC-B-03806.
Extraction and Fourier transform infrared (FT-IR) spectroscopy of extracted antifungal metabolites
FT-IR spectroscopy was performed of extracted metabolites obtained from P. hunanensis SPT26 (Supplementary Fig. 2). The obtained peaks of the FT-IR spectrum were examined as per Griffith (1996). The peak at 3298.29 cm− 1 shows the presence of pyrrole ring. Peak at 2947.5 cm− 1 indicates the stretching vibration of –OH group denoting the existence of alcohol, phenol, and carboxylic acid present in the metabolite sample. The peak at 2915.06 cm− 1 and 2832.96 cm− 1 is attributed to C–H stretching vibration of cyclopropyl group. Presence of peak at 1661.29 indicated the N–H bending, denoting the vibration of primary and secondary amide compounds such as acetamide, carboxamides, benzamides and absorbance peak at 1449.29 cm− 1 attributed to C = O stretching of carboxyl functional group. Peaks at 1112.91 cm− 1 and 1021.13 cm− 1 signify presence of C–F group and alkyl halides. Altogether, resulting spectrum of bacterial metabolites from P. hunanensis SPT26 showed the presence of pyrrole ring, alcohol, phenol, carboxylic acid, alkyl halide, cyclopropyl group and amides group.
Purification of antifungal metabolites from culture supernatant through TLC
Crude metabolite was obtained after separating ethyl acetate layer from separating funnel and evaporating by using rotary evaporator. Crude metabolite extracted from SPT26 was purified using TLC plate of silica kept in solvent until the solvent reached at the top of the plate. Three main spots at distance of 3.8 cm, 4.2 cm and 4.5 cm (Supplementary Fig. 3) with retardation factor (Rf) value 0.76, 0.84 and 0.90 respectively, were found to appear on TLC plate. Three different spots signify the presence of three different compounds in the extracted metabolite, which were named as compounds A, B and C. Using the reference of Rf value, assumption was done for presence of pyrolnitrin, phenol group, phenazines and pyocyanin. The analysis through TLC is not sufficient to identify the obtained compounds; hence compounds separated were further checked for estimating their antifungal activity and LCMS analysis.
Antifungal activity of extracted metabolite of P. hunanensis SPT26 against F. oxysporum
In the present study, P. hunanensis SPT26 was demonstrated to exhibit excellent antifungal properties against F. oxysporum. After the extraction and purification of the metabolite from SPT26, the antifungal compounds A, B and C were observed to inhibit the fungal growth by 68%, 52% and 45% respectively, on MHA plates under salt stress (5% NaCl) (Supplementary Fig. 4). Hence, it can be assumed that the growth of the fungus was majorly limited due to the compound A present in the extracted metabolites, although compounds B and C also inhibited the fungal growth. Outcomes from MIC test showed that 1% of metabolite is the minimum concentration of compounds, which could be employed as biocontrol metabolites for inhibition of growth of F. oxysporum.
Morphological and structural changes in challenged F. oxysporum
Determination of structural and morphological difference within fungal mycelia of control and treated plates was performed with the help of SEM analysis. Fungal mycelia were taken from both plates i.e., zone of inhibition of treated plate and from the control plate. Mycelia of F. oxysporum taken from the control plates were observed to be smooth and healthy with septate structure and no damages (Fig. 1a), while on the other hand, bacterium treated fungus appeared rough, damaged and ruptured. Bacterial cells were visible in the SEM images of fungus inoculated with SPT26 (Fig. 1b). In the images, treatment of compound A was clearly visible to causing damages and disruption in the fungal mycelia (Fig. 1c). In case of treatment with compound B, the mycelia appear to disintegrate and there was shrinking of hyphae, which inhibited the growth of F. oxysporum (Fig. 1d). Disruption of mycelia can be seen in the SEM images, which showed breaking, indicating the lysis of hyphae due to production of antibiotics by P. hunanensis SPT26. By analyzing the SEM results it can be stated that P. hunanensis SPT26 exhibits strong antagonistic activity against F. oxysporum.
SEM images showing (a) Mycelia of control plates with no fungal inoculation, (b) mycelia of fungus treated with P. hunanensis SPT26 showing bacterial cells colonization on the hyphae as indicated by the arrow, (c and d) ruptured mycelia of fungus treated with pyrolnitrin and 1-hydroxyphenazine respectively, arrows indicate the rupture and other deformities
Identification of antibiotics through liquid chromatography-electron spray ionization-mass spectrometry (LC-ESI/MS)
LC-MS analysis of extracted metabolites from P. hunanensis SPT26 was performed in the m/z range of 200–1000. Compounds A, B and C were analysed by LC-ESI/MS, which demonstrated the presence of antifungal compounds, siderophore and antibiotics. Different antifungal compounds produced by SPT26 having the distinct m/z values denote the presence of the specific metabolites. Peaks found in the compound A indicated the presence of pyrolnitrin having m/z ratio 256.6 and 258.6 (Fig. 2), which is well known antibiotic produced by Pseudomonas sp. In vitro studies of biocontrol showed that compound A exhibited the best antifungal properties against F. oxysporum. Hence, this study signifies that pyrolnitrin produced from P. hunanensis SPT26 is highly effective against F. oxysporum. The peaks in compound B exhibiting m/z ratio 197.4 (Fig. 3) were found to be 1- hydroxyphenazine having molecular mass of 197.1. This is a phenazine pigment produced by pseudomonads naturally (Guo et al. 2020). The compound C showed the peak having m/z value 325 (Supplementary Fig. 5) denoting the presence of pyochelin, which can be responsible for controlling the fungal growth. Pyochelin, pyocyanin and 1-hydroxy-phenazine are siderophores known to be produced by pseudomonads (Yasmin et al. 2017; Ngalimat et al. 2021).
Pot experiment and assessment of efficacy of metabolite against F. oxysporum in tomato
Efficiency of P. hunanensis SPT26 and its metabolite were assessed through pot experiment. The characterization of soil physico-chemical properties was performed before and after conducting the pot experiment and results are mentioned in the Table 1. Seed germination rate was lowest in T2 (20%) due to salinity stress and F. oxysporum inoculation, while it was highest in bacterial inoculation alone (90%) and bacterial inoculation with antifungal compounds A and B (90%). The treatment of compound A and compound B (40%) showed germination rate similar to uninoculated control (40%). Hence, it can be concluded that treatment of antifungal compounds had no significant impact on germination rate of seeds, while SPT26 and SPT26 along with compounds A and B significantly increased the germination in comparison with control.
Among the plant growth parameters, root length and shoot length were found to be lowest (7.63 cm and 17.36 cm respectively) in case of F. oxysporum inoculation and highest (28.9 cm and 41.3 cm respectively) when treated with both antifungal compounds along with SPT26. The treatment of compound A and SPT26 in presence of F. oxysporum resulted in significant enhancement of root and shoot length by 173.92% and 79.9% respectively, in comparison to negative control. Similarly, treatment with compound B and SPT26 in presence of the phytopathogen significantly enhanced root length of tomato plants by 193.58% and 161.68% in comparison with negative control (T2) and control (T1) respectively. Treatments with compounds A and B alone but in presence of F. oxysporum were observed to increase root length by 110.09% and shoot length by 40.72% in comparison to negative control (Fig. 4a).
Due to increased root and shoot length in plants with treatment of both antifungal compounds together with SPT26 (T10) the fresh weight (530 g) and dry weight (341.66 g) of plants were also significantly highest in case of T10 in comparison to control (T1) and plants inoculated with F. oxysporum (T2) (Fig. 4b). In case of treatment with compounds A and B in presence of F. oxysporum (T9), fresh weight and dry weight of plants was found to be significantly increased by 53.33% and 16.35% respectively, as compared to treatment of SPT26 alone in presence of F. oxysporum (T4). Treatment of both antifungal compounds along with SPT26 in presence of F. oxysporum increased the fresh weight by 253.33% in comparison with negative control (T2), while it increased by 187.01% in comparison with control (T1). Number of branches in the plants were found maximum i.e., 15 branches, when treated with both antifungal compounds along with inoculation of SPT26 and minimum i.e., 5 branches in the plants with F. oxysporum treatment (T2). While number of branches with inoculation of SPT26 along with compound A and bacterium treatment along with compound B were 14 and 13 respectively. In case of number of fruits per plant treatment of both antifungal compounds (A and B) along with SPT26 and F. oxysporum (39) showed the best results among all the treatments. Inoculation of F. oxysporum (11) and control (15) resulted into the lowest number of fruits per plant (Fig. 4c). The number of fruits in treated plants in increasing order is as following: T2 < T1 < T6 < T9 < T5 < T3 < T4 < T7 = T8 < T10.
The value of RWC in the leaves of the plants was found to be higher when treated with both antifungal compounds along with SPT26 in presence of F. oxysporum (81.37%) and SPT26 and F. oxysporum with treatment of compound B (76.08%) and lowest in the control (65.02%) and F. oxysporum inoculation (54.27%). The increase in the RWC in all the treatments was observed in the following manner: T2 < T1 < T4 < T6 < T5 < T9 < T3 < T7 < T8 < T10. Electrolyte leakage was observed to be highest in F. oxysporum inoculation (74.36%) and control (72.55%), while lowest in the treatment of both antifungal compounds along with SPT26 even in presence of F. oxysporum (57.27%) (Fig. 4d). All the treatments showed the changes in electrolytes leakage in the following order: T10 < T8 < T7 < T6 < T3 < T4 < T9 < T5 < T1 < T2. Hence, the productivity of tomato plants amended with F. oxysporum was found to best when treated with SPT26 together with compounds A and B (T10) and lowest in negative control (T2).
The phytochemical analysis of plant samples also revealed that treatments with SPT26 along with compounds A and B have positive impact on the tomato growth and yield (Table 2). The chlorophyll content was observed to increase in the treated tomato plants with SPT26 and antifungal compounds (T10) by 56.18% in comparison with negative control (T2). Among the antifungal compounds, the plants treated with pyrolnitrin (compound A) were found to enhance chlorophyll content by 39.71%, while 1- hydroxyphenazine (compound B) treatment improved chlorophyll content by 37.09%. Treatment with SPT26 with both antifungal compounds showed the highest chlorophyll content and lowest in negative control as compared with untreated control. Treatment of SPT26 with inoculation of F. oxysporum and SPT26 alone was noticed to exhibit greater chlorophyll content than treatment of antifungal compounds. In the treatment, compound A with SPT26 in presence of F. oxysporum (T7) the chlorophyll A was higher than treatment of compound B with SPT26 and F. oxysporum (T8), whereas chlorophyll B was higher in T8 in comparison to T7. Likewise, carotenoid content was also found to be significantly increased by 83.11% in treatment with combination of compounds A and B along with SPT26 in presence of F. oxysporum in comparison with the negative control. Application of compound B (1- hyroxyphenazine) in plants, along with SPT26 in presence of F. oxysporum increased carotenoid content by 6.16% in comparison to compound A (T7). In the case of phenolic content, the treatment with amalgamation of compounds A and B (T9) showed the maximum value (3.8 and 2.5 times higher than negative control and untreated control respectively). The treatment with SPT26 and compounds A and B showed significant enhancement of 107.74% in the proline content on comparing with negative control. Among all the treatments given to infected plants, the combination of both antifungal compounds with bacterial inoculation (compound A + B + SPT26 + F. oxysporum) showed best results. Flavonoid content was also found to be maximum in case of plants treated with the combination of SPT26 and both antifungal compounds and minimum in plants treated with F. oxysporum i.e., 52.16 mg RE/g (T2) and 25.85 mg RE/g (T10) respectively. Protein content was found to be increased by 119.25% in the combinations of SPT26 and both the antifungal compounds in presence of F. oxysporum when compared with negative control. Likewise, carbohydrate content was also observed to be risen maximum (by 75.21%) in the treatment having bacterial inoculation in combination with both the compounds when compared with negative control.
The effect of compounds A and B and SPT26 on the various biochemical parameters of tomato plants was examined through the heat map (Fig. 5a). Form the study of heat map, it can be clearly witnessed that plants under the stress of fungal infection have the lowest value in all the biochemical parameters, which support the plants to grow and survive. While, on the other hand all the treatments comprising of antifungal compounds and bacterial inoculation showed the best results. It is observed from the heat map that the antifungal compounds have minimum impact on the chlorophyll, carotenoids, flavonoids, and protein but have more impact on the phenol and proline content. Further, from the whole study it can be concluded that the amalgamation of SPT26 and both antifungal compounds showed the best results in physiological and biochemical parameters of the tomato plants, which resulted in the maximum crop yield even in presence of phytopathogen. The significant correlation was studied with the help of Pearson correlation graph (Fig. 5b). The graph showed that chlorophyll b and carotenoid content are less correlated with phenol content in plants. Protein content was found to have no correlation with the number of branches per tomato plant. Branches per plant also appeared to have less correlation with carotenoid and phenol content. Further, flavonoid content was found to have less correlation with phenol content, and chlorophyll b was less correlated with fresh and dry weight of the plants. This study denoted that treatment of antifungal compounds alone can only protect the plant from the fungal infection but combination of the antifungal compounds with the bacterial formulation enhanced the growth and yield while safeguarding the tomato crop from the infection of F. oxysporum.
Graph showing the difference among the various treatments in the analysis of some plant growth parameters (a) root and shoot length, (b) fresh and dry weight of plants, (c) number of fruits and number of branches per plant and, (d) relative water content and electrolytes leakage in the leaves of the plants. The designated treatments are: T1 − Control (uninoculated), T2 − F. oxysporum (only fungal inoculum), T3 − SPT26 (only bacteria), T4 − SPT26 + F. oxysporum, T5 − compound A (pyrolnitrin) + F. oxysporum, T6 − compound B (1-hydroxyphenazine) + F. oxysporum, T7 − SPT26 + compound A (pyrolnitrin) + F. oxysporum, T8 − SPT26 + compound B (1-hydroxyphenazine) + F. oxysporum, T9 − compound A (pyrolnitrin) + compound B (1-hydroxyphenazine) + F. oxysporum, T10 − SPT26 + compound A (pyrolnitrin) + compound B (1-hydroxyphenazine) + F. oxysporum. Error bars represents the standard deviation (SD;±) p value ≤ 0.5
Discussion
Soil salinisation indirectly triggers several deleterious mechanisms responsible for reduced crop productivity. Continuous increase in soil salinization due to irrigation in agricultural fields with saline water is the primary reason behind plant physiology and morphology alterations, which make plants susceptible towards the phytopathogens (Fatima et al. 2022). Tomato is a commercially significant vegetable crop grown worldwide. Due to the infection of phytopathogens, the crop is facing significant loss before and after harvesting. Under saline conditions and hot climates, disease severity increases due to enhanced virulence of pathogens (Pandey and Senthil-Kumar 2019). Fusarium root rot, vascular wilt, and damping-off are common diseases caused by F. oxysporum, which are the cause of reduction in crop yield and quality. Among different biocontrol mechanisms of Pseudomonas species, antibiotic production, and their role in retarding the fungal infections in the crops can be very important (Mishra and Arora 2018). However, there is very limited research on the role of secondary metabolites produced by PGPR for enhancement of plant growth and productivity under combined impact of salinity and biotic stress.
Salt-tolerant PGPR P. aeruginosa HG28–5 was reported to promote tomato production and fruit biomass under salt stressed conditions by regulating osmotic and hormonal balance with increasing photosynthetic rate and antioxidant activity (Dong et al. 2024). Halotolerant strains Enterobacter 64S1 and Pseudomonas 42P4 were found to ameliorate the salinity stress and promoted the growth and yield of tomato by maintaining nitrogen fixation, mineral solubilization and other major processes under stressful conditions (Pérez-Rodriguez et al. 2022). In this study, the halotolerant bacterium SPT26, identified as P. hunanensis, was isolated from rhizospheric soil of tomato grown in saline soil and was selected based on its salt tolerance (8% NaCl) and antagonism against F. oxysporum. We aimed to explore the antifungal metabolites produced by P. hunanensis to control the growth of F. oxysporum, causing root rot and vascular wilt in tomatoes. Although abundant research has been done signifying the vital role of pseudomonads in the biocontrol of various pathogenic fungal strains causing tremendous loss to crop yield (Barahona et al. 2011; Durairaj et al. 2018; Fatima et al. 2022; Wang et al. 2021a, c), studies regarding the biocontrol of phytopathogens in presence of salt stress are not very common. Few studies are available in which P. hunanensis has been documented to promote plant growth under saline conditions and help in biodegradation of phenolic and hydrocarbon compounds in contaminated soil (Alali et al. 2021; Wang et al. 2021b), however, its role as a biocontrol agent under saline conditions is not reported.
Antifungal metabolite production from fluorescent pseudomonads could be an effective method for controlling and treating infections of fungal phytopathogens under normal and saline conditions (Arora et al. 2020; Mishra et al. 2021). In this context, we checked the potency of halotolerant P. hunanensis SPT26 against F. oxysporum under in vitro conditions and the bacterium was found capable of inhibiting the fungal growth. Three antifungal compounds namely pyrolnitrin, 1- hydroxyphenazine and pyochelin were detected to be produced by SPT26. In previous studies, P. fluorescens was found to promote plant growth and 2,4-Diacetylphloroglucinol (DAPG) production by it inhibited the growth of Rhizoctonia solani causing disease in common beans (Ahmadzadeh and Tehrani 2009). In the study performed by Karmegham et al. (2020), P. aeruginosa was reported to produce the derivative compound of phenazine showing antifungal activity against R. solani, Macrophomina phaseolina, F. oxysporum, Alternaria alternata and Sclerotium rolfsii causing infections in soybean.
a Heatmap to show the effect of SPT26 and both antifungal compounds on the biochemical parameters in the tomato plants. b Correlogram showing p-value (*p ≤ 0.05 and **p ≤ 0.01) was prepared to show a significant correlation within different variables. The designated treatments are: T1 − Control (uninoculated), T2 − F. oxysporum (only fungal inoculum), T3 − SPT26 (only bacteria), T4 − SPT26 + F. oxysporum, T5 − compound A (pyrolnitrin) + F. oxysporum, T6 − compound B (1-hydroxyphenazine) + F. oxysporum, T7 − SPT26 + compound A (pyrolnitrin) + F. oxysporum, T8 − SPT26 + compound B (1-hydroxyphenazine) + F. oxysporum, T9 − compound A (pyrolnitrin) + compound B (1-hydroxyphenazine) + F. oxysporum, T10 − SPT26 + compound A (pyrolnitrin) + compound B (1-hydroxyphenazine) + F. oxysporum. Various plant biochemical parameters checked are designated as: ChlA Chlorophyll A, ChlB Chlorophyll B, Crt Carotenoid content, Phe Total phenolic content, Flv flavonoid content, Prt protein content, Crb carbohydrate, Prl proline content
Stress conditions make the plant more susceptible towards fungal diseases likewise, salinity induces the generation of ROS, which impairs the defence system of plants. Antifungal metabolites produced from microbes significantly protect crops from numerous infectious diseases, further promoting plant health and growth under stressed conditions (Arora et al. 2020). In our study, pyrolnitrin, 1- hydroxyphenazine and pyochelin produced by P. hunanensis SPT26 were found to hamper the growth of F. oxysporum, as the biocontrol activity of all the three crude compounds was checked separately. Results obtained from SEM revealed that pyrolnitrin (compound A) and 1-hydroxyphenazine (compound B) inhibited the fungal growth by impairing the mycelial growth of fungus. Gao et al. (2018) reported that production of antifungal compounds from Pseudomonas strain QBA5 inhibited the fungal growth by hampering the conidia germination, germ tube elongation along with supressing the mycelial growth of Botrytis cinerea causing grey mold disease in tomato leaves. Antifungal activity of pyrolnitrin produced by Burkholderia cepacia has been reported to be effective against Colletotrichum sp. (Park et al. 2004), Phtytophthora capsica, F. oxysporum and R. solani by retarding the growth of fungal mycelia (Jung et al. 2018). 1-hydroxyphenazine produced by Pseudomonas chlororaphis was reported to show antagonistic activity against Sclerotium rolfsii, causing stem rot in peanuts (Liu et al. 2022). Pyochelin is a siderophore reported to be produced by pseudomonads which contributes to the biocontrol of diseases by limiting the supply of iron for pathogens. Michavila et al. (2017) reported Pseudomonas protegens CS1 to produce pyochelin and its inhibitory effects against citrus canker in lemon.
Elevation of salt concentration in soil makes adverse changes in the soil structure and properties, which resultantly makes soil barren and unproductive. Salt stress in soil has detrimental impact on the plant growth, survival, and productivity due to changes in soil properties like, water holding capacity, pH, EC, hydraulic properties, nutrient availability, moisture content and microbial diversity (Bidalia et al. 2019; Zhang et al. 2019; Tang et al. 2020; Rahimi et al. 2021; Arora et al. 2024; Bharti et al. 2024). We investigated the changes in soil properties after treatments given in different combinations including SPT26, and antifungal compounds (produced by the bacterium SPT26) to tomato plants growing in saline soil. The investigation confirmed that bacterial formulation (SPT26) significantly augmented the soil quality and productivity by improving the water holding capacity, pH, EC, total available nitrogen, soil available phosphorus and microbial diversity. This could be possible due to suppression of pathogenic fungus and improvement of microbial diversity participating in major process in soil like, nitrogen fixation, solubilization of essential elements and production of phytohormones and other metabolites. Likewise, the study conducted by Tienda et al. (2020) found that application of 2-hexyl, 5-propil resorcinol producing Pseudomonas chlororaphis PCL1606 in the avocado infected with Rosellinia necatrix causing white rot disease, inhibited the fungal growth and enhanced the soil microbial diversity and organic matter. P. fluorescence is reported to improve the soil bulk density, soil porosity which make the soil favourable for bacterial population and enhanced the bacterial cell density. Enhanced soil structure promoted the microbial activities in the soil consequently intensifying the soil health and fertility (Juyal et al. 2021). Another study revealed that inoculation of Bacillus subtilis and P. fluorescence improved the soil quality by upregulating the enzymatic activities and increased the amount of available nitrogen and ammonium in the soil (Ng et al. 2022).
Compounds A (pyrolnitrin) and B (1-hydroxyphenazine) were further tested for pot trial experiments, as both compounds showed the better biocontrol activity in comparison with compound C (pyochelin). In the field study, various combinations of the halotolerant strain P. hunanensis SPT26 along with pyrolnitrin and 1-hydroxyphenazine were checked, and their effect on plant biochemical and growth parameters was observed. Salinity affects the primary and secondary mechanisms related to plant growth and productivity. Seed germination rate is lowered due to biotic and abiotic stresses, which cause hyperosmotic stress and ionic disturbances (Arora et al. 2020). Our study revealed that P. hunanensis SPT26 alone and along with antifungal metabolites enhances the germination rate of tomato seeds under saline conditions, while treatment of antifungal metabolites alone doesn’t have much impact on the same.
Increased salt concentration in the soil makes the nutrients unavailable for plants, reducing plant growth by decreasing the root and shoot length and impacting numerous other major growth factors (Tanveer et al. 2020). In the current study, the root and shoot length of tomato plants grown in saline conditions and biotic stress were observed to reduce significantly, while plant growth and yield were found significantly improved when treated with a combination of SPT26 and the bacterial metabolites (pyrolnitrin and 1-hydroxyphenazine). The treatment of compound B (1-hydroxyphenazine) with SPT26 showed better root and shoot growth in comparison with compound A (pyrolnitrin) along with SPT26. Previous studies have also reported the role of 1-hydroxyphenazine, phenazine-1-carboxylic acid (PCA), pyocyanin, pyrolnitrin and other antifungal and antimicrobial metabolites in plant growth promotion in cow pea and pigeon pea (George et al. 2015; Jishma et al. 2021). The antifungal compounds played notable role in plant survival and growth, which resulted in enhancement in tomato yield in presence of F. oxysporum under salt stress.
Salt stress is responsible for ionic and nutritional imbalance, which results in the replacement of salt ions with nutrients, adversely impacting photosynthesis in plants, and lowering the chlorophyll content in leaves (Yang et al. 2022). In the current study, SPT26 was observed to promote the chlorophyll and carotenoid contents in leaves even under saline conditions, which may be due to the bioavailability of nutrients made possible by bioinoculant. Various biochemical traits of plants, like carbohydrates, protein, proline, and flavonoid contents, are affected under saline conditions (Habibi et al. 2023; Alzahib et al. 2021; Gharsallah et al. 2016; Botella et al. 2021). Total phenolic content in tomato plants has been reported to increase with increasing salt concentration to recover the oxidative damage by stressful conditions (Bacha et al. 2017). Our study found that high salt concentration in soil with inoculation of F. oxysporum lowered the phenolic content in the plant, making the plant vulnerable towards fusarium wilt under salinity. On the other hand, treatment of both antifungal metabolites showed higher phenolic content, which is the indication of higher antioxidant activity securing the plants from the damages caused by free radicals generated under stressed conditions. In previous studies, reduction in carbohydrate and protein content in the tomato plant surviving under elevated salt concentration have been reported due to nutritional imbalance caused by Na+ and Cl− ions (Habibi et al. 2023; Alzahib et al. 2021). The present study found that combination of salinity (abiotic) and biotic stress (F. oxysporum) resulted in lowering of carbohydrate and protein content. On the other hand, treatment of SPT26 along with both antifungal compounds were observed to have highest carbohydrate and protein content as SPT26 eliminated the nutritional imbalance, and antifungal compounds helped the plant to fight against the infection of F. oxysporum. Plants growing under salinity and in presence of F. oxysporum showed the lowest proline and flavonoid content, which diminished the ability of the plant to cope with the stressed conditions (Gharsallah et al. 2016; Botella et al. 2021). Correlation graph showed lower correlation of phenol content with chlorophyll and carotenoid content. It has been reported that phenol content increases with increasing salt stress, while chlorophyll content reduces at higher salt levels, which is due to retarded photosynthetic rate (Alzahib et al. 2021). Phenolic content showed positive correlation with flavonoid content as it also appeared to increase with rising salt concentrations. Hernández-Herrera et al. (2022) observed the strong correlation between phenols and flavonoids in the tomato grown under salinity stress.
From the results, it can be concluded that the production of metabolites from SPT26 under stressful conditions made the plant capable of growing and resisting biotic stress by F. oxysporum and abiotic stress due to salinity. The biodiversity of microorganisms is very low in saline soil, making it infertile and lacking organic matter. The study shows that the strain P. hunanensis SPT26 producing pyrolnitrin, pyochelin and hyroxyphenazine, inhibits F. oxysporum and diseases caused by it in tomato under salt stress conditions and improves soil and plant properties. The study also shows that pyrolnitrin played a major role in the suppression of root rot in plant as well as in providing nutrients available environment to the plant.
Conclusion
Improper use of pesticides is imposing threat upon the food security and environmental sustainability. Hence there is an urge to replace the use of pesticides to prevent various health and environmental hazards. Employing beneficial microorganisms for enhancing the soil fertility and crop protection under biotic and abiotic stress is crucial to fulfil the upcoming demands of increasing population and ensure food security. The present study demonstrated that secondary metabolites produced by P. hunanensis SPT26 can be utilized for control of phytopathogens such as F. oxysporum. Results from study revealed that the bacterial strain has potential to protect the tomato crop from fusarium root rot and fusarium wilt as well as promoting the plant growth under saline conditions. Outcome of the work signifies that amendments of the bioformulation with the bacterial anti-fungal metabolites such as pyrolnitrin and hyroxyphenazine gives best results for cultivation of crops grown in soil affected by biotic and abiotic stresses.
Data availability
All data generated or analysed during this study are included in this published article and the further required raw data supporting the research study will be made available by the authors upon request.
References
Ábrahám E, Hourton-Cabassa C, Erdei L, Szabados L (2010) Methods for determination of proline in plants. Plant Stress Tolerance: Methods Protocols 317–331. https://doi.org/10.1007/978-1-60761-702-0_20
Ahmadzadeh M, Tehrani AS (2009) Evaluation of fluorescent pseudomonads for plant growth promotion, antifungal activity against Rhizoctonia solani on common bean, and biocontrol potential. Biol Control 48(2):101–107. https://doi.org/10.1016/j.biocontrol.2008.10.012
AlAli HA, Khalifa A, Almalki M (2021) Plant growth-promoting rhizobacteria from Ocimum basilicum improve growth of Phaseolus vulgaris and Abelmoschus esculentus. S Afr J Bot 139:200–209. https://doi.org/10.1016/j.sajb.2021.02.01922
Alzahib RH, Migdadi HM, Al Ghamdi AA, Alwahibi MS, Ibrahim AA, Al-Selwey WA (2021) Assessment of morpho-physiological, biochemical and antioxidant responses of tomato landraces to salinity stress. Plants 10(4):696. https://doi.org/10.3390/plants10040696
Amore A, Parameswaran B, Kumar R, Birolo L, Vinciguerra R, Marcolongo L, Elena I, Francesco LC, Pandey A, Faraco V (2015) Application of a new xylanase activity from Bacillus amyloliquefaciens XR44A in brewer’s spent grain saccharification. J Chem Technol Biotechnol 90(3):573–581. https://doi.org/10.1002/jctb.4589
Arora NK, Fatima T, Mishra J, Mishra I, Verma S, Verma R, Verma M, Bhattacharya A, Verma P, Mishra P, Bharti C (2020) Halo-tolerant plant growth promoting rhizobacteria for improving productivity and remediation of saline soils. J Adv Res 26:69–82. https://doi.org/10.1016/j.jare.2020.07.003
Arora NK, Mishra J, Singh P, Fatima T (2024) Salt-tolerant plant growth‐promoting Pseudomonas atacamensis KSS‐6 in combination with organic manure enhances rice yield, improves nutrient content and soil properties under salinity stress. J Basic Microbiol 64(6):2300767. https://doi.org/10.1002/jobm.202300767
Bacha H, Tekaya M, Drine S, Guasmi F, Touil L, Enneb H et al (2017) Impact of salt stress on morpho-physiological and biochemical parameters of Solanum lycopersicum cv. Microtom leaves. S Afr J Bot 108:364–369. https://doi.org/10.1016/j.sajb.2016.08.018
Barahona E, Navazo A, Martínez-Granero F, Zea-Bonilla T, Pérez-Jiménez RM, Martín M, Rivilla R (2011) Pseudomonas fluorescens F113 mutant with enhanced competitive colonization ability and improved biocontrol activity against fungal root pathogens. Appl Environ Microbiol 77(15):5412–5419. https://doi.org/10.1128/AEM.00320-11
Bharti C, Fatima T, Mishra P, Verma P, Bhattacharya A, Alaylar B, Arora NK (2024) Salt-tolerant endophytic Bacillus altitudinis NKA32 with ACC deaminase activity modulates physiochemical mechanisms in rice for adaptation in saline ecosystem. Environ Sust 7:231–249. https://doi.org/10.1007/s42398-024-00316-w
Bidalia A, Vikram K, Yamal Rao KS (2019) Effect of salinity on soil nutrients and plant health. Salt Stress, Microbes, and Plant Interactions: Causes and Solution: Volume 1, 273–297.https://doi.org/10.1007/978-981-13-8801-9_13
Botella MÁ, Hernández V, Mestre T, Hellín P, García-Legaz MF, Rivero RM et al (2021) Bioactive compounds of tomato fruit in response to salinity, heat and their combination. Agriculture 11(6):534. https://doi.org/10.3390/agriculture11060534
Castano R, Borrero C, Trillas MI, Avilés M (2013) Selection of biological control agents against tomato fusarium wilt and evaluation in greenhouse conditions of two selected agents in three growing media. Biocontrol 58:105–116. https://doi.org/10.1007/s10526-012-9465-z
Chen Y, Shen X, Peng H, Hu H, Wang W, Zhang X (2015) Comparative genomic analysis and phenazine production of Pseudomonas chlororaphis, a plant growth-promoting rhizobacterium. Genom data 4:33–42. https://doi.org/10.1016/j.gdata.2015.01.006
Dada EO, Aruwa CE (2014) Microorganisms associated with urine contaminated soils around lecture theatres in Federal University of Technology, Akure, Nigeria. Int J Appl Microbiol Biotechnol Rese 2(6):79–85
Dong H, Wang Y, Di Y, Qiu Y, Ji Z, Zhou T et al (2024) Plant growth-promoting rhizobacteria Pseudomonas aeruginosa HG28-5 improves salt tolerance by regulating Na+/K + homeostasis and ABA signaling pathway in tomato. Microbiol Res 283:127707. https://doi.org/10.1016/j.micres.2024.127707
Durairaj K, Velmurugan P, Park JH, Chang WS, Park YJ, Senthilkumar P, Choi KM, Lee JH, Oh BT (2018) An investigation of biocontrol activity Pseudomonas and Bacillus strains against Panax ginseng root rot fungal phytopathogens. Biol Control 125:138–146. https://doi.org/10.1016/j.biocontrol.2018.05.021
Fatima T, Arora NK (2021) Pseudomonas entomophila PE3 and its exopolysaccharides as biostimulants for enhancing growth, yield and tolerance responses of sunflower under saline conditions. Microbiol Res 244:126671. https://doi.org/10.1016/j.micres.2020.126671
Fatima T, Mishra I, Verma R, Arora NK (2020) Mechanisms of halotolerant plant growth promoting Alcaligenes sp. involved in salt tolerance and enhancement of the growth of rice under salinity stress. 3 Biotech 10:1–12. https://doi.org/10.1007/s13205-020-02348-5
Fatima S, Hameed M, Ahmad F, Ahmad MSA, Khalil S, Munir M, Ashraf M, Ahmad I, Ahmad KS, Kaleem M (2022a) Structural and functional responses in widespread distribution of some dominant grasses along climatic elevation gradients. Flora 289:152034. https://doi.org/10.1016/j.flora.2022.152034
Fatima T, Verma P, Verma S, Alaylar B, Arora NK (2022b) Role of metabolites produced by plant growth-promoting bacteria in biocontrol of phytopathogens under saline conditions. In: Microbial BioTechnology for sustainable agriculture volume 1. Singapore: Springer Nature, pp 287–324. https://doi.org/10.1007/978-981-16-4843-4_9
Fuller AT, Mellows G, Woolford M, Banks GT, Barrow KD, Chain EB (1971) Pseudomonic acid: an antibiotic produced by Pseudomonas fluorescens. Nature 234(5329):416–417. https://doi.org/10.1038/234416a0
Gao P, Qin J, Li D, Zhou S (2018) Inhibitory effect and possible mechanism of a Pseudomonas strain QBA5 against gray mold on tomato leaves and fruits caused by Botrytis cinerea. PLoS One 13(1):e0190932. https://doi.org/10.1371/journal.pone.0190932
George N, Bhandari V, Reddy DP, Sharma P (2015a) Molecular and phylogenetic analysis revealed new genotypes of Theileria annulata parasites from India. Parasit Vectors 8:1–8. https://doi.org/10.1186/s13071-015-1075-z
George E, Kumar SN, Jacob J, Bommasani B, Lankalapalli RS, Morang P et al (2015b) Characterization of the bioactive metabolites from a plant growth-promoting rhizobacteria and their exploitation as antimicrobial and plant growth-promoting agents. Appl Biochem Biotechnol 176:529–546. https://doi.org/10.1007/s12010-015-1593-3
Gharsallah C, Fakhfakh H, Grubb D, Gorsane F (2016) Effect of salt stress on ion concentration, proline content, antioxidant enzyme activities and gene expression in tomato cultivars. AoB Plants 8:plw055. https://doi.org/10.1093/aobpla/plw055
Griffith DW (1996) Synthetic calibration and quantitative analysis of gas-phase FT-IR spectra. Appl Spectrosc 50(1):59–70. https://doi.org/10.1366/0003702963906627
Guo S, Liu R, Wang W, Hu H, Li Z, Zhang X (2020) Designing an artificial pathway for the biosynthesis of a novel phenazine N-oxide in Pseudomonas chlororaphis HT66. ACS Synth Biol 9(4):883–892. https://doi.org/10.1021/acssynbio.9b00515
Habibi N, Aryan S, Amin MW, Sanada A, Terada N, Koshio K (2023) Potential benefits of seed priming under salt stress conditions on physiological, and biochemical attributes of micro-tom tomato plants. Plants 12(11):2187. https://doi.org/10.3390/plants12112187
Hernández-Herrera RM, Sánchez-Hernández CV, Palmeros-Suárez PA, Ocampo-Alvarez H, Santacruz-Ruvalcaba F, Meza-Canales ID, Becerril-Espinosa A (2022) Seaweed extract improves growth and productivity of tomato plants under salinity stress. Agronomy 12(10):2495. https://doi.org/10.3390/agronomy12102495
Jishma P, Shad KS, Athulya EC, Sachidanandan P, Radhakrishnan EK (2021) Rhizospheric Pseudomonas spp. with plant growth promotion and antifungal properties against Sclerotium rolfsii mediated pathogenesis in Vigna unguiculata. Plant Biotechnol Rep 15(4):483–491. https://doi.org/10.1007/s11816-021-00687-0
Jung BK, Hong SJ, Park GS, Kim MC, Shin JH (2018) Isolation of Burkholderia cepacia JBK9 with plant growth-promoting activity while producing pyrrolnitrin antagonistic to plant fungal diseases. Appl Biol Chem 61:173–180. https://doi.org/10.1007/s13765-018-0345-9
Juyal A, Otten W, Baveye PC, Eickhorst T (2021) Influence of soil structure on the spread of Pseudomonas fluorescens in soil at microscale. Eur J Soil Sci 72(1):141–153
Kandoliya UK, Vakharia DN (2013) Molecular characterization of Pseudomonas fluorescens inhibiting the chickpea wilt pathogen in vitro. Int J Plant Prot 6(2):241–246
Karimi E, Mehrabanjoubani P, Keshavarzian M, Oskoueian E, Jaafar HZ, Abdolzadeh A (2014) Identification and quantification of phenolic and flavonoid components in straw and seed husk of some rice varieties (Oryza sativa L.) and their antioxidant properties. J Sci Food Agric 94(11):2324–2330. https://doi.org/10.1002/jsfa.6567
Karmegham N, Vellasamy S, Natesan B, Sharma MP, Al Farraj DA, Elshikh MS (2020) Characterization of antifungal metabolite phenazine from rice rhizosphere fluorescent pseudomonads (FPs) and their effect on sheath blight of rice. Saudi J Biol Sci 27(12):3313–3326. https://doi.org/10.1016/j.sjbs.2020.10.007
Kumar S, Rao R (2017) Protocols for soil sampling, soil and water analysis. Director. ICAR-Central Soil Salinity Research Institute, Karnal
Kumar P, Sharma PK (2020) Soil salinity and food security in India. Fron Sustain Food Syst 4:533781. https://doi.org/10.3389/fsufs.2020.533781
Kumar Y, Sharanagat VS, Singh L, Mani S (2020) Effect of germination and roasting on the proximate composition, total phenolics, and functional properties of black chickpea (Cicer arietinum). Legum Sci 2(1):e20. https://doi.org/10.1002/leg3.20
Larkin RP, Fravel DR (1998) Efficacy of various fungal and bacterial biocontrol organisms for control of Fusarium wilt of tomato. Plant Dis 82(9):1022–1028. https://doi.org/10.1094/PDIS.1998.82.9.1022
Liu F, Yang S, Xu F, Zhang Z, Lu Y, Zhang J, Wang G (2022) Characteristics of biological control and mechanisms of Pseudomonas chlororaphis zm-1 against peanut stem rot. BMC Microbiol 22(1):1–13. https://doi.org/10.1186/s12866-021-02420-x
Lowry O, Rosebrough N, Farr AL, Randall R (1951) Protein measurement with the Folin phenol reagent. J biol chem 193(1):265–275. https://doi.org/10.1016/S0021-9258(19)52451-6
Meliani H, Makhloufi A, Cherif A, Mahjoubi M, Makhloufi K (2022) Biocontrol of toxinogenic Aspergillus flavus and Fusarium oxysporum f. sp. albedinis by two rare saharan actinomycetes strains and LC-ESI/MS-MS profiling of their antimicrobial products. Saudi J Biol Sci 29(6):103288. https://doi.org/10.1016/j.sjbs.2022.103288
Michavila G, Adler C, De Gregorio PR, Lami MJ, Di Caram MC, Zenoff AM, Vincent PA (2017) Pseudomonas protegens CS 1 from the lemon phyllosphere as a candidate for citrus canker biocontrol agent. Plant Biol 19(4):608–617. https://doi.org/10.1111/plb.12556
Mishra J, Arora NK (2018) Secondary metabolites of fluorescent pseudomonads in biocontrol of phytopathogens for sustainable agriculture. Appl Soil Ecol 125:35–45. https://doi.org/10.1016/j.apsoil.2017.12.004
Mishra P, Mishra J, Arora NK (2021) Plant growth promoting bacteria for combating salinity stress in plants–recent developments and prospects: a review. Microbiol Res 252:126861. https://doi.org/10.1016/j.micres.2021.126861
Mishra P, Mishra J, Arora NK (2024) Salt tolerant Pseudomonas taiwanensis PWR-1 in combination with a reduced dose of mineral fertilizers improves the nutritional and antioxidant properties of wheatgrass grown in saline soil. World J Microbiol Biotechnol 40(1):11. https://doi.org/10.1007/s11274-023-03806-x
Mohammed AF, Oloyede AR, Odeseye AO (2020) Biological control of bacterial wilt of tomato caused by Ralstonia solanacearum using Pseudomonas species isolated from the rhizosphere of tomato plants. Arch Phytopathol Plant Prot 53(1–2):1–16. https://doi.org/10.1080/03235408.2020.1715756
Murugan L, Krishnan N, Venkataravanappa V, Saha S, Mishra AK, Sharma BK, Rai AB (2020) Molecular characterization and race identification of Fusarium oxysporum f. sp. lycopersici infecting tomato in India. 3 Biotech 10:1–12. https://doi.org/10.1007/s13205-020-02475-z
Nandakumar R, Babu S, Viswanathan R, Sheela J, Raguchander T, Samiyappan R (2001) A new bio-formulation containing plant growth promoting rhizobacterial mixture for the management of sheath blight and enhanced grain yield in rice. Biocontrol 46:493–510. https://doi.org/10.1023/A:1014131131808
Ng CWW, Yan WH, Tsim KWK, San So P, Xia YT, To CT (2022) Effects of Bacillus subtilis and Pseudomonas fluorescens as the soil amendment. Heliyon 8(11). https://doi.org/10.1016/j.heliyon.2022.e11674
Ngalimat MS, Mohd Hata E, Zulperi D, Ismail SI, Ismail MR, Mohd Zainudin NAI, Yusof MT (2021) Plant growth-promoting bacteria as an emerging tool to manage bacterial rice pathogens. Microorganisms 9(4):682. https://doi.org/10.3390/microorganisms9040682
Ors S, Ekinci M, Yildirim E, Sahin U, Turan M, Dursun A (2021) Interactive effects of salinity and drought stress on photosynthetic characteristics and physiology of tomato (Lycopersicon esculentum L.) seedlings. South Afr J Bot 137:335–339. https://doi.org/10.1016/j.sajb.2020.10.031
Pandey P, Senthil-Kumar M (2019) Plant-pathogen interaction in the presence of abiotic stress: what do we know about plant responses? Plant Physiol Rep 24(4):541–549. https://doi.org/10.1007/s40502-019-00483-7
Park JH, Choi GJ, Lee SW, Jang KS, Choi YH, Chung YR, Kim JC (2004) In vivo antifungal activity of pyrrolnitrin isolated from Burkholderia cepacia EB215 with antagonistic activity towards Colletotrichum species. Kor J Mycol 32(1):31–38. https://doi.org/10.4489/KJM.2004.32.1.031
Perez C (1990) Antibiotic assay by agar-well diffusion method. Acta Biol Med Exp 15:113–115
Pérez-Rodriguez MM, Pontin M, Piccoli P, Lobato Ureche MA, Gordillo MG, Funes‐Pinter I, Cohen AC (2022) Halotolerant native bacteria Enterobacter 64S1 and Pseudomonas 42P4 alleviate saline stress in tomato plants. Physiol Plant 174(4):e13742. https://doi.org/10.1111/ppl.13742
Porra RJ, Thompson WAA, Kriedemann PE (1989) Determination of accurate extinction coefficients and simultaneous equations for assaying chlorophylls a and b extracted with four different solvents: verification of the concentration of chlorophyll standards by atomic absorption spectroscopy. Biochim et Biophysic Acta (BBA)-Bioenerg 975(3):384–394. https://doi.org/10.1016/S0005-2728(89)80347-0
Prakash J, Arora NK (2021) Novel metabolites from Bacillus safensis and their antifungal property against Alternaria alternata. Antonie Van Leeuwenhoek 114(8):1245–1258. https://doi.org/10.1007/s10482-021-01598-4
Rahimi L, Amanipoor H, Battaleb-Looie S (2021) Effect of salinity of irrigation water on soil properties (abadan plain, SW Iran). Geocarto Int 36(16):1884–1903. https://doi.org/10.1080/10106049.2019.1678678
Ramírez-Cariño HF, Guadarrama-Mendoza PC, Sánchez-López V, Cuervo-Parra JA, Ramírez-Reyes T, Dunlap CA, Valadez-Blanco R (2020) Biocontrol of Alternaria alternata and Fusarium oxysporum by Trichoderma asperelloides and Bacillus paralicheniformis in tomato plants. Antonie Van Leeuwenhoek 113(9):1247–1261. https://doi.org/10.1007/s10482-020-01433-2
Rosales AM, Thomashow L, Cook RJ, Mew TW (1995) Isolation and identification of antifungal metabolites produced by rice-associated antagonistic Pseudomonas spp. Phytopathol 85(9):1028–1032. https://doi.org/10.1094/Phyto-85-1028
Schiessl KT, Hu F, Jo J, Nazia SZ, Wang B, Price-Whelan A, Min W, Dietrich LE (2019) Phenazine production promotes antibiotic tolerance and metabolic heterogeneity in Pseudomonas aeruginosa biofilms. Nat Commun 10(1):762. https://doi.org/10.1038/s41467-019-08733-w
Senguttuvan J, Paulsamy S, Karthika K (2014) Phytochemical analysis and evaluation of leaf and root parts of the medicinal herb, Hypochaeris radicata L. for in vitro antioxidant activities. Asian Pac J Trop Biomed 4:S359–S367. https://doi.org/10.12980/APJTB.4.2014C1030
Tamura K, Dudley J, Nei M, Kumar S (2007) MEGA 4: Molecular Evolutionary Genetics Analysis (MEGA) software version 4.0. Mol Biol Evol 24:1596–1599. https://doi.org/10.1093/molbev/msm092
Tang S, She D, Wang H (2020) Effect of salinity on soil structure and soil hydraulic characteristics. Can J Soil Sci 101(1):62–73. https://doi.org/10.1139/cjss-2020-0018
Tanveer K, Gilani S, Hussain Z, Ishaq R, Adeel M, Ilyas N (2020) Effect of salt stress on tomato plant and the role of calcium. J Plant Nutr 43(1):28–35. https://doi.org/10.1080/01904167.2019.1659324
https://www.statista.com/statistics/682055/asia-pacific-tomato-production-by-country/#:~:text=In%202022%2C%20the%20largest%20producer,tons%20of%20tomatoes%20in%202022
Wang SY, Shi XC, Chen X, Laborda P, Zhao YY, Liu FQ, Laborda P (2021a) Biocontrol ability of phenazine-producing strains for the management of fungal plant pathogens: a review. Biol Control 155:104548. https://doi.org/10.1016/j.biocontrol.2021.104548
Wang Y, Zhang W, Zhang Z, Wang W, Xu S, He X (2021b) Isolation, identification and characterization of phenolic acid-degrading bacteria from soil. J Appl Microbiol 131(1):208–220. https://doi.org/10.1111/jam.14956
Wang C, Wang Y, Wang L, Fan W, Zhang X, Chen X, Wang J (2021c) Biocontrol potential of volatile organic compounds from Pseudomonas chlororaphis ZL3 against postharvest graymold caused by Botrytis cinerea on Chinese cherry. Biol Control 159:104613. https://doi.org/10.1016/j.biocontrol.2021.104613
Whistler CA, Pierson LS III (2003) Repression of phenazine antibiotic production in Pseudomonas aureofaciens strain 30–84 by RpeA. J Bacteriol 185(13):3718–3725. https://doi.org/10.1128/jb.185.13.3718-3725.2003
Xu W, Wang K, Wang H, Liu Z, Shi Y, Gao Z, Wang Z (2020) Evaluation of the biocontrol potential of Bacillus sp. WB against Fusarium oxysporum f. sp. niveum. Biol Control 147:104288. https://doi.org/10.1016/j.biocontrol.2020.104288
Yang Y, Yao Y, Li J, Zhang J, Zhang X, Hu L et al (2022) Trehalose alleviated salt stress in tomato by regulating ROS metabolism, photosynthesis, osmolyte synthesis, and trehalose metabolic pathways. Front Plant Sci 13:772948. https://doi.org/10.3389/fpls.2022.772948
Yasmin S, Hafeez FY, Mirza MS, Rasul M, Arshad HM, Zubair M, Iqbal M (2017) Biocontrol of bacterial leaf blight of rice and profiling of secondary metabolites produced by rhizospheric Pseudomonas aeruginosa BRp3. Front Microbiol 8:1895. https://doi.org/10.3389/fmicb.2017.01895
Zhang WW, Chong WANG, Rui XUE, Wang LJ (2019) Effects of salinity on the soil microbial community and soil fertility. J Integ Agric 18(6):1360–1368. https://doi.org/10.5555/20193349291
Zhang QX, Kong XW, Li SY, Chen XJ, Chen XJ (2020) Antibiotics of Pseudomonas protegens FD6 are essential for biocontrol activity. Australa Plant Pathol 49:307–317. https://doi.org/10.1007/s13313-020-00696-7
Acknowledgements
The authors are thankful to University Sophisticated Instrumentation Centre (USIC), Babasaheb Bhimrao Ambedkar University, for providing facility to conduct SEM and FTIR studies. The authors are thankful to National Centre for Microbial Resource (NCMR), Pune for 16s rRNA sequencing of isolates for their identification. The authors are also thankful to CSIR-Central Drug Research Institute (CDRI), Lucknow for LCMS analysis.
Funding
The authors are thankful to University Grants Commission (UGC) Grant no. F.14–34/2011 (CPP-II) and Department of Science and Technology (DST), New Delhi, India SEED (Grant no. SEED/SCSP/2019/61BBAU/G), for providing funding assistance to carry out this work.
Author information
Authors and Affiliations
Contributions
NKA: Supervision, Conceptualization, Resources, Validation, Reviewing and Editing. PV: Investigation, Methodology, Data analysis and compilation, Writing- original draft, Editing- original draft, Graphs and Figures. AB: Writing- original draft, Editing- original draft, Data analysis. CB: Writing- original draft, Editing- original draft, Data analysis.
Corresponding author
Ethics declarations
Competing interests
The authors declare no competing interests.
Additional information
Publisher’s Note
Springer Nature remains neutral with regard to jurisdictional claims in published maps and institutional affiliations.
Electronic supplementary material
Below is the link to the electronic supplementary material.
Rights and permissions
Springer Nature or its licensor (e.g. a society or other partner) holds exclusive rights to this article under a publishing agreement with the author(s) or other rightsholder(s); author self-archiving of the accepted manuscript version of this article is solely governed by the terms of such publishing agreement and applicable law.
About this article
Cite this article
Verma, P., Bhattacharya, A., Bharti, C. et al. Antifungal metabolites produced by Pseudomonas hunanensis SPT26 effective in biocontrol of fusarium wilt of Lycopersicum esculentum under saline conditions. World J Microbiol Biotechnol 40, 305 (2024). https://doi.org/10.1007/s11274-024-04092-x
Received:
Accepted:
Published:
DOI: https://doi.org/10.1007/s11274-024-04092-x